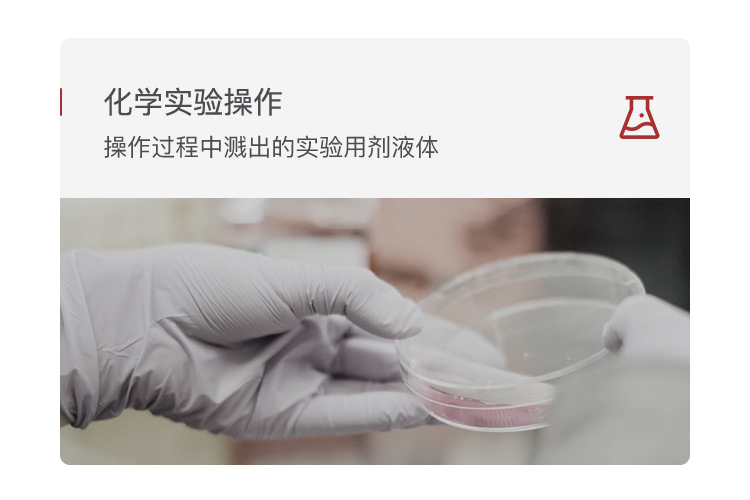

¥25.0200
累计评价
0累计评价
0
梅思安 10245179 V-Gard带孔豪华型 ABS安全帽 一指键帽衬 PVC吸汗带 E型下颌带-白色
¥ 73.26

梅思安 10245171 V-Gard带孔豪华型 PE安全帽 一指键帽衬 针织尼龙E型下颌带
¥ 54.81

卫安 高硅氧防火毯 1个厚 1.5*1.5
¥ 166.60

国产普通 2111黄布二层全掌手套(BC)-均码
¥ 9.00

安科 PVC安全警示标识标牌 已接地 有人工作 200*160mm 挂钩款
¥ 18.00

JESERY/杰苏瑞 KIT345 移动式化学品应急推车(化学型) 吸附容量120L
¥ 3600.00

梅思安 10245179 V-Gard带孔豪华型 ABS安全帽 一指键帽衬 PVC吸汗带 E型下颌带-白色
¥73.26

梅思安 10245171 V-Gard带孔豪华型 PE安全帽 一指键帽衬 针织尼龙E型下颌带
¥54.81

卫安 高硅氧防火毯 1个厚 1.5*1.5
¥166.60

国产普通 2111黄布二层全掌手套(BC)-均码
¥9.00

安科 PVC安全警示标识标牌 已接地 有人工作 200*160mm 挂钩款
¥18.00

JESERY/杰苏瑞 KIT345 移动式化学品应急推车(化学型) 吸附容量120L
¥3600.00
0 件
¥ 0
镜片颜色:淡蓝色;
产品叙述:镜片单片式,主要用于遮光、防尘;
适合亚洲人宽阔镜框设计,更兼具多重防护性能;
骑行与户外运动:防雾气、风沙、杂质的干扰侵袭;
建筑材料装修加工:防金属切割,木材切割过程中的碎屑;
化学实验操作:防操作过程中溅出的试验用剂液体。